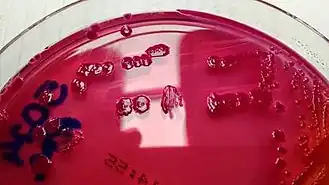
Description de l'image Phytobacter diazotrophicus.jpg.

Phytobacter
Phytobacter
| Domaine | Bacteria |
|---|---|
| Embranchement | Pseudomonadota |
| Classe | Gammaproteobacteria |
| Ordre | Enterobacterales |
| Famille | Enterobacteriaceae |
- Metakosakonia Alnajar & Gupta 2017
Phytobacter est un genre de bacilles Gram négatifs (BGN) de la famille des Enterobacteriaceae. Son nom, composé de la racine grecque phyto- (φυτόν,-oῦ : plante) et du néolatin bacter (bactérie), peut se traduire par « bactérie végétale ». Il fait référence à l'origine endophyte de l'espèce type, isolée pour la première fois des tissus internes d'une espèce de riz sauvage[1].
Liste d'espèces
Selon la LPSN (3 novembre 2022)[2] :
- Phytobacter diazotrophicus Zhang et al. 2017 – espèce type ;
- Phytobacter massiliensis (Lagier et al. 2014) Ma et al. 2021 ;
- Phytobacter palmae Madhaiyan et al. 2020 ;
- Phytobacter ursingii Pillonetto et al. 2018.
Notes et références
- ↑ Zhang GX et al. « Diverse endophytic nitrogen-fixing bacteria isolated from wild rice Oryza rufipogon and description of Phytobacter diazotrophicus gen. nov. sp. nov » Arch Microbiol. 2008;189:431-439. https://doi.org/10.1007/s00203-007-0333-7
- ↑ List of Prokaryotic names with Standing in Nomenclature (LPSN), consulté le 3 novembre 2022.
- Portail de la microbiologie